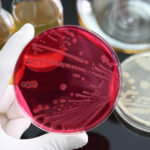

Beschreibung
Eine rezidivierende depressive Störung, auch bekannt als rezidivierende Depression, ist eine psychische Erkrankung, die durch mehrere Episoden depressiver Symptome gekennzeichnet ist. Diese Episoden können in Schwere und Dauer variieren. Zu den häufigen Symptomen gehören anhaltende Gefühle von Traurigkeit, Verlust von Interesse oder Freude, Veränderungen des Appetits und des Schlafverhaltens, Müdigkeit, Konzentrationsschwierigkeiten und Gedanken an Wertlosigkeit oder Selbstmordgedanken.
Was die Prävalenz angeht, so betrifft die rezidivierende depressive Störung einen erheblichen Teil der Bevölkerung weltweit. Nach Angaben der Weltgesundheitsorganisation (WHO) sind Depressionen eine der Hauptursachen für Behinderungen weltweit und betreffen etwa 264 Millionen Menschen. Die Störung kann in jedem Alter auftreten, wobei der Beginn typischerweise in der späten Jugend oder im frühen Erwachsenenalter liegt.
Die Komplikationen, die mit einer rezidivierenden depressiven Störung einhergehen, können tiefgreifende Auswirkungen auf verschiedene Aspekte des Lebens eines Menschen haben. Die Erkrankung kann zu einer Beeinträchtigung des sozialen und beruflichen Funktionierens, zu einem erhöhten Risiko des Drogenmissbrauchs, zu Beziehungsproblemen und zu einer höheren Rate komorbider psychiatrischer Störungen, wie etwa Angststörungen, führen.
Die Diagnose einer rezidivierenden depressiven Störung erfordert eine umfassende Beurteilung durch eine psychiatrische Fachkraft. Klinische Befragungen, die Bewertung der Symptome und die Berücksichtigung der Krankengeschichte des Betroffenen sind wichtige Bestandteile. Es gibt keine spezifischen Labortests oder bildgebenden Untersuchungen, um die Erkrankung zu diagnostizieren, da sie in erster Linie von einer gründlichen psychiatrischen Beurteilung abhängt.
Die Behandlung einer rezidivierenden depressiven Störung umfasst häufig einen multimodalen Ansatz. Dazu kann eine Psychotherapie gehören, z. B. eine kognitive Verhaltenstherapie (CBT), eine interpersonelle Therapie (IPT) oder eine psychodynamische Therapie. Zusätzlich können je nach Symptomen und Ansprechen auf die Behandlung pharmakologische Maßnahmen wie antidepressive Medikamente verschrieben werden.
Die Ursachen für rezidivierende depressive Störungen sind multifaktoriell und umfassen ein komplexes Zusammenspiel genetischer, biologischer, psychologischer und umweltbedingter Faktoren. Genetische Veranlagung, Veränderungen der Hirnchemie und der Neurotransmitterfunktion, Stressfaktoren im Leben und eine Vorgeschichte mit Traumata oder ungünstigen Lebensereignissen können zur Entwicklung der Störung beitragen.
Auch wenn es nicht möglich ist, wiederkehrende depressive Störungen vollständig zu verhindern, können bestimmte Strategien dazu beitragen, das Risiko zu verringern und das allgemeine Wohlbefinden zu fördern. Dazu gehören ein gesunder Lebensstil, regelmäßige körperliche Betätigung, die Pflege enger sozialer Beziehungen, die frühzeitige Behandlung depressiver Symptome und die Entwicklung wirksamer Bewältigungsmechanismen zur Bewältigung von Stress und emotionalen Herausforderungen.
Neurowissenschaftliche und psychologische Grundlagen der rezidivierenden depressiven Störung
Bei rezidivierenden depressiven Störungen sind verschiedene Regionen und neuronale Schaltkreise des Gehirns betroffen, die zur Manifestation der Symptome und zu Störungen der emotionalen Verarbeitung beitragen. Eine der wichtigsten betroffenen Regionen ist der präfrontale Kortex, der für exekutive Funktionen, Emotionsregulation, Entscheidungsfindung und kognitive Prozesse zuständig ist. Bei Personen mit rezidivierenden depressiven Störungen kann es zu Veränderungen im präfrontalen Kortex kommen, die zu Schwierigkeiten bei der Emotionsregulierung und zu kognitiven Beeinträchtigungen führen.
Darüber hinaus spielt das limbische System, insbesondere die Amygdala und der Hippocampus, eine entscheidende Rolle bei der emotionalen Verarbeitung und der Gedächtnisbildung. Eine Dysregulation dieser Strukturen kann zu den emotionalen Störungen und negativen Vorurteilen beitragen, die bei Personen mit rezidivierenden depressiven Störungen beobachtet werden. Bei Menschen mit Depressionen wurden eine erhöhte Aktivität in der Amygdala, die mit der Verarbeitung negativer Emotionen in Verbindung gebracht wird, und Veränderungen im Hippocampus, der an der Gedächtnis- und Stimmungsregulation beteiligt ist, beobachtet.
Aus psychologischer Sicht kann eine rezidivierende depressive Störung durch verschiedene Faktoren ausgelöst werden. Länger andauernde Stressfaktoren wie traumatische Erlebnisse, chronischer Lebensstress oder negative Ereignisse in der Kindheit können Veränderungen in der Gehirnfunktion und den neuronalen Schaltkreisen auslösen, die mit der Emotionsregulation und der Stressreaktion in Zusammenhang stehen. Negative kognitive Verzerrungen, wie verzerrte Denkmuster und eine negative Selbstwahrnehmung, können ebenfalls zur Entwicklung und Aufrechterhaltung depressiver Symptome beitragen.
Psychologische Theorien, wie das kognitive Modell der Depression, gehen davon aus, dass negative kognitive Schemata, maladaptive Überzeugungen und kognitive Verzerrungen eine wichtige Rolle bei der Entstehung und Aufrechterhaltung wiederkehrender depressiver Störungen spielen. Diese kognitiven Faktoren beeinflussen die Wahrnehmung des Einzelnen von sich selbst, der Welt und der Zukunft, was zu negativen Interpretationen von Erfahrungen und einer Verstärkung der depressiven Symptome führt.
Arten und Symptome
Die rezidivierende depressive Störung umfasst verschiedene Typen, die sich in Schweregrad, Dauer und den damit verbundenen Symptomen unterscheiden. Das Verständnis der verschiedenen Typen ist entscheidend für eine genaue Diagnose und eine angemessene Behandlungsplanung. In diesem Abschnitt werden die häufigsten Formen rezidivierender depressiver Störungen, ihre jeweiligen Symptome und die Auswirkungen auf das Wohlbefinden der Betroffenen erläutert.
Rezidivierende depressive Störung, aktuelle leichte Episode:
Zu den Symptomen einer leichten Episode gehören anhaltende Gefühle von Traurigkeit, Verlust von Interesse oder Freude an Aktivitäten, Veränderungen des Appetits oder des Gewichts, Schlafstörungen, Müdigkeit, Konzentrationsschwierigkeiten und ein allgemeines Gefühl der Wertlosigkeit. Die Betroffenen können leichte Beeinträchtigungen im täglichen Leben erfahren, sind aber in der Regel in der Lage, ihre Aufgaben zu bewältigen und sich an regelmäßigen Aktivitäten zu beteiligen.
Rezidivierende depressive Störung, aktuelle mittelschwere Episode:
Bei einer mittelschweren Episode sind die Symptome ausgeprägter und beeinträchtigen das tägliche Funktionieren erheblich. Zusätzlich zu den bereits erwähnten Symptomen einer leichten Episode können die Betroffenen vermehrt Gefühle der Hoffnungslosigkeit, ein vermindertes Selbstwertgefühl, psychomotorische Unruhe oder Verlangsamung sowie wiederkehrende Gedanken an Tod oder Selbstmord haben. Die Symptome beeinträchtigen die täglichen Aktivitäten, die Arbeit und die Beziehungen.
Rezidivierende depressive Störung, aktuelle schwere Episode ohne psychotische Symptome:
Eine schwere Episode ohne psychotische Symptome ist durch intensive und anhaltende Symptome gekennzeichnet, die alle Aspekte des Lebens einer Person beeinträchtigen. Zu den Symptomen gehören tiefe Traurigkeit, Anhedonie (Verlust des Interesses an früher beliebten Aktivitäten), erhebliche Veränderungen von Appetit und Gewicht, Schlaflosigkeit oder Hypersomnie, psychomotorische Unruhe oder Retardierung, Müdigkeit, übermäßige Schuldgefühle oder Selbstvorwürfe, Konzentrationsschwierigkeiten und wiederkehrende Gedanken an Tod oder Selbstmord.
Rezidivierende depressive Störung, aktuelle schwere Episode mit psychotischen Symptomen:
Bei diesem Typus treten die Symptome einer schweren Episode zusammen mit zusätzlichen psychotischen Merkmalen auf. Zu den psychotischen Symptomen können Halluzinationen (Wahrnehmung von Dingen, die nicht da sind) und Wahnvorstellungen (feste, falsche Überzeugungen) gehören. Diese Symptome können sehr belastend sein und tragen zu einem höheren Risiko bei, sich selbst oder andere zu verletzen. Ein rasches Eingreifen und eine angemessene Behandlung sind in diesen Fällen unerlässlich.
Komplikationen:
Eine rezidivierende depressive Störung kann zu erheblichen Komplikationen führen, die sowohl das körperliche als auch das psychische Wohlbefinden beeinträchtigen. Zu den häufigsten Komplikationen gehören:
Selbstmordrisiko: Menschen mit rezidivierenden depressiven Störungen, insbesondere solche mit schweren Episoden oder psychotischen Symptomen, haben ein höheres Risiko für Suizidgedanken und Suizidversuche. Eine engmaschige Überwachung und geeignete Maßnahmen sind entscheidend, um diesem Risiko zu begegnen.
Soziale und berufliche Beeinträchtigung: Die Symptome einer rezidivierenden depressiven Störung können soziale Beziehungen stören und die berufliche Tätigkeit beeinträchtigen. Für die Betroffenen kann es schwierig sein, persönliche Beziehungen aufrechtzuerhalten, gute Leistungen bei der Arbeit oder in der Schule zu erbringen und ihren täglichen Pflichten nachzukommen.
Gleichzeitige psychische Störungen: Eine rezidivierende depressive Störung tritt häufig zusammen mit anderen psychischen Erkrankungen auf, z. B. mit Angststörungen, Drogenkonsum und Essstörungen. Das Vorliegen mehrerer Störungen kann die Diagnose und die Behandlungsplanung erschweren.
Auswirkungen auf die körperliche Gesundheit: Länger anhaltende Depressionen können sich auf die körperliche Gesundheit auswirken und zu Schlafstörungen, Appetit- und Gewichtsveränderungen, einem geschwächten Immunsystem und einer erhöhten Anfälligkeit für andere Erkrankungen führen.
Das Verständnis der verschiedenen Arten und potenziellen Komplikationen einer rezidivierenden depressiven Störung ist entscheidend für eine genaue Diagnose, geeignete Behandlungsmaßnahmen und eine kontinuierliche Unterstützung.
Untersuchung und Diagnostik
Eine genaue Diagnose der rezidivierenden depressiven Störung ist entscheidend, um eine angemessene Behandlung einzuleiten und die Betroffenen bei der effektiven Bewältigung ihrer Erkrankung zu unterstützen. Der diagnostische Prozess umfasst eine umfassende Bewertung, die eine klinische Untersuchung, die Erhebung der Krankengeschichte und in einigen Fällen auch Labortests und bildgebende Verfahren einschließt. Dieser Abschnitt gibt einen Überblick über die diagnostischen Verfahren zur Erkennung einer rezidivierenden depressiven Störung.
Klinische Untersuchung:
Die Diagnose einer rezidivierenden depressiven Störung beginnt in der Regel mit einer klinischen Untersuchung, die von einem Psychiater oder einer psychiatrischen Fachkraft durchgeführt wird. Die Untersuchung umfasst eine gründliche Beurteilung der Krankengeschichte und der psychiatrischen Symptome der Person.
Die psychiatrische Begutachtung ist ein wichtiger Teil der klinischen Untersuchung. Sie umfasst eine gezielte Bewertung der aktuellen und früheren psychiatrischen Symptome der Person. Der Gesundheitsdienstleister bewertet das Vorhandensein und die Dauer depressiver Symptome, um festzustellen, ob sie die Kriterien für eine rezidivierende depressive Störung erfüllen. Dabei werden Intensität und Dauer der Traurigkeit, Interessenverlust, Schlaf- und Appetitveränderungen, Schuldgefühle oder Wertlosigkeit, Gedanken an Tod oder Selbstmord sowie alle durch diese Symptome verursachten Funktionseinschränkungen berücksichtigt. Der Psychiater bewertet auch die Auswirkungen dieser Symptome auf die sozialen, beruflichen und sonstigen Funktionsbereiche der Person.
Um die Diagnose einer rezidivierenden depressiven Störung zu erhalten, müssen die Symptome des Betroffenen bestimmte Kriterien erfüllen, die im Diagnostischen und Statistischen Handbuch Psychischer Störungen (DSM-5) der American Psychiatric Association aufgeführt sind. Diese Kriterien umfassen Folgendes:
Vorliegen von mindestens zwei schweren depressiven Episoden im Abstand von mindestens zwei Monaten ohne signifikante Symptome.
Die Symptome verursachen erheblichen Leidensdruck oder Beeinträchtigungen in sozialen, beruflichen oder anderen wichtigen Funktionsbereichen.
Die Symptome lassen sich nicht besser durch andere medizinische Erkrankungen, Substanzkonsum oder einen Trauerfall erklären.
Durch die Beurteilung der Symptome einer Person und die Bewertung der Einhaltung dieser diagnostischen Kriterien können medizinische Fachkräfte eine rezidivierende depressive Störung genau diagnostizieren und einen geeigneten Behandlungsplan entwickeln.
Labortests und Bildgebung:
Labortests und bildgebende Untersuchungen werden in der Regel nicht zur direkten Diagnose einer rezidivierenden depressiven Störung eingesetzt. Sie können jedoch durchgeführt werden, um andere Erkrankungen auszuschließen, die die depressiven Symptome nachahmen oder zu ihnen beitragen können. Relevante Tests können sein:
Blutuntersuchungen: Diese können durchgeführt werden, um die Schilddrüsenfunktion zu beurteilen, einen Vitaminmangel auszuschließen oder zugrundeliegende Erkrankungen zu ermitteln, die zu den depressiven Symptomen beitragen könnten.
Neurobildgebung: In bestimmten Fällen können bildgebende Verfahren des Gehirns wie Magnetresonanztomographie (MRT) oder Computertomographie (CT) eingesetzt werden, um die Gehirnstruktur zu beurteilen und Anomalien zu erkennen.
Therapie und Behandlungen
Eine wirksame Behandlung der rezidivierenden depressiven Störung umfasst einen umfassenden Ansatz, der darauf abzielt, die Symptome zu lindern, das allgemeine Wohlbefinden zu verbessern und das Risiko künftiger Episoden zu verringern. Vorrangiges Ziel ist es, den Betroffenen zu helfen, ihr Leben wieder in den Griff zu bekommen, ihre Symptome zu bewältigen und ihre Lebensqualität zu verbessern.
Psychotherapie:
Kognitiv-behaviorale Therapie (CBT): Die kognitive Verhaltenstherapie ist ein weit verbreiteter psychotherapeutischer Ansatz, der sich darauf konzentriert, negative Gedankenmuster und Verhaltensweisen, die mit Depressionen einhergehen, zu erkennen und zu verändern. Durch die CBT lernen die Betroffenen, negative Überzeugungen zu hinterfragen, adaptivere Bewältigungsstrategien zu entwickeln und positive Veränderungen in ihrem Alltag vorzunehmen. Diese Therapie hilft den Betroffenen, ihre Gedanken, Gefühle und Verhaltensweisen besser zu verstehen und wirksame Strategien zur Bewältigung depressiver Symptome zu entwickeln.
Psychodynamische Psychotherapie: Bei der psychodynamischen Psychotherapie liegt der Schwerpunkt auf der Erforschung unbewusster Gedanken, Gefühle und früher Lebenserfahrungen, die zu wiederkehrenden depressiven Episoden beitragen können. Dieser therapeutische Ansatz zielt darauf ab, die Selbstwahrnehmung und die Einsicht in die zugrunde liegenden Ursachen der Depression zu verbessern. Durch die Untersuchung früherer Beziehungen, ungelöster Konflikte und unbewusster Muster kann der Einzelne ein tieferes Verständnis für seine emotionalen Kämpfe gewinnen und gesündere Bewältigungsmöglichkeiten entwickeln.
Interpersonelle Therapie (IPT): Die IPT konzentriert sich auf die Verbesserung zwischenmenschlicher Beziehungen und die Bewältigung sozialer Schwierigkeiten, die zu depressiven Episoden beitragen. Diese Therapie hilft dem Einzelnen, seine Kommunikationsfähigkeiten zu verbessern, Konflikte zu bewältigen und gesündere Beziehungen zu anderen zu entwickeln. Durch die Behandlung von zwischenmenschlichen Problemen und die Verbesserung der sozialen Unterstützung kann die IPT depressive Symptome lindern und zukünftige Rückfälle verhindern.
Medikation:
Antidepressiva werden häufig an Personen mit rezidivierenden depressiven Störungen verschrieben. Selektive Serotonin-Wiederaufnahmehemmer (SSRI), Serotonin-Noradrenalin-Wiederaufnahmehemmer (SNRI) und andere Klassen von Antidepressiva können je nach den Symptomen und dem Ansprechen auf die Behandlung des Patienten verschrieben werden. Medikamente helfen bei der Regulierung von Gehirnchemikalien, die mit der Stimmung in Verbindung stehen, und können depressive Symptome wirksam verringern. Es ist wichtig, eng mit einem Arzt zusammenzuarbeiten, um die für den jeweiligen Patienten am besten geeignete Medikation und Dosierung zu ermitteln.
Andere therapeutische Interventionen:
Neben der Psychotherapie und der medikamentösen Behandlung können auch andere therapeutische Maßnahmen die Gesamtbehandlung der rezidivierenden depressiven Störung unterstützen. Dazu können gehören:
Änderung der Lebensweise: Die Förderung gesunder Lebensgewohnheiten wie regelmäßiger Sport, ausgewogene Ernährung, ausreichender Schlaf und Techniken zum Stressabbau können sich positiv auf die Stimmung und das allgemeine Wohlbefinden auswirken.
Selbsthilfegruppen: Die Teilnahme an Selbsthilfegruppen oder die Unterstützung durch Gleichgesinnte kann den Betroffenen ein Gefühl der Gemeinschaft und des Verständnisses vermitteln und es ihnen ermöglichen, Erfahrungen auszutauschen und Unterstützung von anderen zu erhalten, die mit ähnlichen Herausforderungen konfrontiert waren.
Stressbewältigung: Das Erlernen wirksamer Stressbewältigungstechniken, wie z. B. Entspannungsübungen, Achtsamkeit und Zeitmanagement, kann den Betroffenen helfen, ihr Stressniveau zu senken und besser mit Auslösern umzugehen, die zu depressiven Episoden beitragen können.
Komplementäre und alternative Therapien: Manche Menschen profitieren von komplementären und alternativen Therapien wie Akupunktur, Yoga, Meditation oder pflanzlichen Präparaten. Diese Ansätze sollten mit einem Arzt besprochen werden, um sicherzustellen, dass sie sicher und in Verbindung mit anderen Behandlungsstrategien eingesetzt werden.
Es ist wichtig, dass Menschen mit rezidivierenden depressiven Störungen eng mit medizinischem Fachpersonal zusammenarbeiten, um einen individuellen Behandlungsplan zu entwickeln.
Ursachen und Risikofaktoren
Die Ursachen für rezidivierende depressive Störungen sind multifaktoriell, d. h. es handelt sich um ein komplexes Zusammenspiel genetischer, biologischer, psychologischer und umweltbedingter Faktoren. Das Verständnis dieser Faktoren kann Aufschluss über die Entwicklung der Störung geben und dazu beitragen, wirksame Behandlungsansätze zu finden.
Ursachen:
Die rezidivierende depressive Störung wird nicht durch einen einzigen Faktor verursacht, sondern ist das Ergebnis einer Kombination mehrerer Ursachen. So gibt es beispielsweise Hinweise auf eine genetische Veranlagung für rezidivierende depressive Störungen. Bestimmte genetische Variationen können die Anfälligkeit einer Person für die Entwicklung dieser Erkrankung erhöhen. Es wurden jedoch keine spezifischen Gene als direkte Ursache identifiziert, was darauf hindeutet, dass genetische Faktoren zusammen mit anderen Einflüssen zur Erkrankung beitragen.
Biologisch gesehen geht die rezidivierende depressive Störung mit einer Dysregulation verschiedener Neurotransmitter wie Serotonin, Noradrenalin und Dopamin einher, die bei der Stimmungsregulation eine entscheidende Rolle spielen. Ein Ungleichgewicht dieser Neurotransmitter kann die Kommunikation zwischen Gehirnregionen beeinträchtigen, die an der emotionalen Verarbeitung und Stimmungsregulierung beteiligt sind, was zu depressiven Symptomen führt.
Darüber hinaus wurden bei Personen mit rezidivierenden depressiven Störungen Anomalien in der Struktur und Funktion bestimmter Hirnregionen wie dem präfrontalen Kortex, dem Hippocampus und der Amygdala beobachtet. Diese Veränderungen wirken sich auf die emotionale Verarbeitung, die Stressreaktion und die Stimmungsregulation aus.
Psychologische Faktoren tragen zur Entwicklung und Aufrechterhaltung einer rezidivierenden depressiven Störung bei. Personen mit einer Vorgeschichte von negativen Kindheitserfahrungen, Traumata oder Missbrauch sind möglicherweise anfälliger für die Entwicklung dieser Störung. Darüber hinaus können bestimmte kognitive Muster, wie z. B. ein negativer Denkstil, geringes Selbstwertgefühl und übermäßige Selbstkritik, das Risiko für depressive Episoden erhöhen.
Umweltfaktoren wie stressige Lebensereignisse, der Verlust eines geliebten Menschen, Beziehungsschwierigkeiten oder finanzielle Belastungen können bei anfälligen Personen depressive Episoden auslösen oder verschlimmern. Chronischer Stress, soziale Isolation und fehlende soziale Unterstützung tragen ebenfalls zur Entwicklung der Erkrankung bei.
Risikofaktoren:
Auch wenn die genauen Ursachen der rezidivierenden depressiven Störung nach wie vor komplex und vielschichtig sind, erhöhen bestimmte Faktoren das Risiko, an der Krankheit zu erkranken:
Familiäre Vorbelastung: Wenn ein Verwandter ersten Grades, z. B. ein Elternteil oder ein Geschwisterkind, an einer Depression erkrankt ist, erhöht sich das Risiko, eine rezidivierende depressive Störung zu entwickeln.
Persönliche Vorgeschichte: Personen mit einer Vorgeschichte von Depressionen oder anderen psychischen Erkrankungen sind anfälliger für wiederkehrende depressive Episoden.
Geschlecht: Frauen haben eine höhere Prävalenz rezidivierender depressiver Störungen als Männer. Hormonelle Schwankungen, Lebensübergänge (wie Schwangerschaft oder Menopause) und gesellschaftliche Faktoren können zu diesem Geschlechtsunterschied beitragen.
Chronische Krankheiten: Bestimmte chronische Erkrankungen wie Herz-Kreislauf-Erkrankungen, Diabetes oder chronische Schmerzen können das Risiko für die Entwicklung einer rezidivierenden depressiven Störung erhöhen.
Substanzmissbrauch: Substanzmissbrauch, einschließlich Alkohol- oder Drogenmissbrauch, ist stark mit einem erhöhten Risiko für rezidivierende depressive Störungen verbunden.
Soziale Faktoren: Soziale Faktoren wie ein niedriger sozioökonomischer Status, mangelnde soziale Unterstützung und ein eingeschränkter Zugang zur Gesundheitsversorgung können zur Entwicklung der Störung beitragen.
Es ist wichtig zu beachten, dass das Vorhandensein dieser Risikofaktoren keine Garantie für die Entwicklung einer rezidivierenden depressiven Störung darstellt.
Krankheitsverlauf und Prognose
Das Verständnis des Krankheitsverlaufs der rezidivierenden depressiven Störung ist für eine wirksame Behandlung von entscheidender Bedeutung. In diesem Abschnitt erfahren Sie, wie sich die Krankheit typischerweise entwickelt, wie sie fortschreitet und welche Prognose sie hat.
Krankheitsverlauf:
Der Verlauf einer rezidivierenden depressiven Störung kann von Person zu Person unterschiedlich sein, und die Dauer und Schwere der depressiven Episoden können variieren. Es gibt jedoch allgemeine Muster, die den typischen Verlauf der Krankheit skizzieren:
Beginn: Die rezidivierende depressive Störung beginnt häufig in der späten Jugend oder im frühen Erwachsenenalter, kann aber in jedem Alter auftreten. Die erste depressive Episode kann durch ein bestimmtes Ereignis ausgelöst werden oder spontan auftreten. Der Schweregrad der ersten Episode kann von leicht bis schwer reichen.
Wiederkehrende Episoden: Nach der ersten Episode neigen Menschen mit einer rezidivierenden depressiven Störung dazu, im Laufe ihres Lebens mehrere depressive Episoden zu erleben. Diese Episoden können in Dauer, Häufigkeit und Intensität variieren. Auch der zeitliche Abstand zwischen den Episoden kann variieren: Bei manchen Menschen liegen die Episoden Monate oder Jahre auseinander, während sie bei anderen schneller wiederkehren.
Remission und Perioden zwischen den Episoden: Zwischen den depressiven Episoden können die Betroffenen Perioden teilweiser oder vollständiger Remission erleben, die durch eine Verringerung oder das Fehlen depressiver Symptome gekennzeichnet sind. Diese Zeiträume zwischen den einzelnen Episoden können unterschiedlich lang sein, wobei einige Personen längere, andere kürzere Phasen der Stabilität haben können.
Schweregrad und Dauer: Der Schweregrad und die Dauer depressiver Episoden können variieren. Leichte Episoden können mit wenigen depressiven Symptomen einhergehen, die das tägliche Funktionieren nicht wesentlich beeinträchtigen. Mittelschwere Episoden können zu spürbaren Beeinträchtigungen in sozialen, beruflichen oder schulischen Bereichen führen. Schwere Episoden können schwächend sein und dazu führen, dass alltägliche Aktivitäten nicht mehr ausgeführt werden können und ein erhöhtes Risiko für Selbstverletzungen oder Selbstmord besteht.
Prognose:
Die Prognose für rezidivierende depressive Störungen ist von Person zu Person unterschiedlich und wird von verschiedenen Faktoren beeinflusst, darunter:
Schweregrad der Episoden: Der Schweregrad der depressiven Episoden kann die Gesamtprognose beeinflussen. Personen mit leichteren und kürzeren Episoden haben tendenziell eine bessere Prognose als Personen mit schwereren und längeren Episoden.
Ansprechen auf die Behandlung: Eine rechtzeitige und angemessene Behandlung spielt eine entscheidende Rolle bei der Bewältigung rezidivierender depressiver Störungen. Personen, die wirksame Maßnahmen wie Psychotherapie und/oder Medikamente erhalten und auf die Behandlung ansprechen, haben eine bessere Prognose.
Komorbidität: Das Vorhandensein anderer psychischer Störungen wie Angststörungen oder Substanzkonsumstörungen kann den Verlauf der rezidivierenden depressiven Störung verkomplizieren und die Prognose beeinträchtigen.
Soziale Unterstützung: Eine angemessene soziale Unterstützung, einschließlich eines unterstützenden Netzwerks aus Familie und Freunden, kann sich positiv auf die Prognose auswirken. Starke soziale Unterstützungssysteme können die Widerstandsfähigkeit erhöhen und Ressourcen für die Bewältigung depressiver Episoden bereitstellen.
Prävention
Die Prävention spielt eine entscheidende Rolle bei der Verringerung der Belastung durch wiederkehrende depressive Störungen und der Förderung des psychischen Wohlbefindens. Dieser Abschnitt gibt einen Überblick über verschiedene Präventionsmethoden und -strategien, die darauf abzielen, das Auftreten oder Wiederauftreten depressiver Episoden zu verhindern. Durch die Umsetzung dieser Ansätze kann der Einzelne proaktive Schritte zum Schutz seiner psychischen Gesundheit unternehmen.
Psychoedukation:
Die Bereitstellung genauer Informationen über rezidivierende depressive Störungen für Einzelpersonen und ihre Familien kann dazu beitragen, das Bewusstsein und das Verständnis für diese Erkrankung zu erhöhen. Psychoedukation umfasst die Aufklärung über Symptome, Risikofaktoren und verfügbare Behandlungen und befähigt die Betroffenen, frühe Anzeichen zu erkennen und rechtzeitig zu intervenieren.
Frühzeitige Erkennung und Intervention:
Die frühzeitige Erkennung und Behandlung von depressiven Symptomen ist für die Prävention entscheidend. Angehörige der Gesundheitsberufe, Pädagogen und Gemeindemitglieder sollten darin geschult werden, Anzeichen von Depressionen zu erkennen und die Betroffenen zur Beurteilung und Behandlung an geeignete psychosoziale Dienste zu verweisen.
Psychologische Interventionen:
Verschiedene evidenzbasierte Psychotherapien können dazu beitragen, das Wiederauftreten von depressiven Episoden zu verhindern. Kognitive Verhaltenstherapie (CBT), interpersonelle Therapie (IPT) und psychodynamische Therapie haben sich bei der Verringerung des Rückfallrisikos als wirksam erwiesen. Diese Therapien zielen darauf ab, die Bewältigungs- und Problemlösungsfähigkeiten zu verbessern und die zugrunde liegenden emotionalen und zwischenmenschlichen Schwierigkeiten anzugehen.
Medikation:
In einigen Fällen können Antidepressiva verschrieben werden, um wiederkehrende depressive Episoden zu verhindern. Selektive Serotonin-Wiederaufnahmehemmer (SSRI), Serotonin-Noradrenalin-Wiederaufnahmehemmer (SNRI) und andere Antidepressiva können helfen, die Stimmung zu stabilisieren und das Risiko eines Rückfalls zu verringern. Die Medikation sollte von einer qualifizierten medizinischen Fachkraft verschrieben und überwacht werden.
Änderungen der Lebensweise:
Eine gesunde Lebensweise kann dazu beitragen, wiederkehrende depressive Episoden zu verhindern. Regelmäßige körperliche Betätigung, eine ausgewogene Ernährung, ausreichend Schlaf und Stressbewältigung können sich positiv auf das psychische Wohlbefinden auswirken. Der Verzicht auf übermäßigen Alkohol- oder Drogenkonsum ist ebenfalls wichtig, da er depressive Symptome verschlimmern kann.
Soziale Unterstützung und Beziehungen:
Der Aufbau und die Pflege starker sozialer Unterstützungsnetze kann als Schutzfaktor gegen wiederkehrende depressive Störungen dienen. Bedeutsame Beziehungen zu Familie, Freunden und Selbsthilfegruppen können emotionale Unterstützung bieten, das Gefühl der Isolation verringern und die allgemeine psychische Gesundheit fördern.
Stressbewältigung:
Das Erlernen wirksamer Stressbewältigungstechniken wie Entspannungsübungen, Achtsamkeitsmeditation und Stressabbaustrategien kann den Betroffenen helfen, mit den täglichen Stressfaktoren umzugehen und eine Eskalation der depressiven Symptome zu verhindern.
Regelmäßige Nachsorge und Aufrechterhaltung: Personen, die bereits früher depressive Episoden erlebt haben, sollten eine regelmäßige Nachsorge durch psychosoziale Fachkräfte in Betracht ziehen. Eine kontinuierliche Überwachung, eine Anpassung der Behandlungspläne, falls erforderlich, und eine offene Kommunikation mit den Gesundheitsdienstleistern können helfen, mögliche Auslöser zu erkennen und Rückfälle zu verhindern.
Zusammenfassung
Die rezidivierende depressive Störung, auch bekannt als rezidivierende Depression, ist eine schwierige psychische Erkrankung, die durch wiederholte depressive Episoden gekennzeichnet ist. In diesem umfassenden Leitfaden haben wir verschiedene Aspekte der rezidivierenden depressiven Störung untersucht, darunter Definition, Symptome, Arten, Diagnose, Behandlung, Ursachen, Risikofaktoren, Krankheitsverlauf, Prognose und Präventionsstrategien. Das Leben mit einer rezidivierenden depressiven Störung kann entmutigend sein, aber es gibt Hoffnung. Bei frühzeitiger Erkennung, richtiger Diagnose und umfassender Behandlung können Betroffene ihre Symptome wirksam in den Griff bekommen und das Risiko eines erneuten Auftretens verringern. Psychotherapie, Medikamente, Änderungen des Lebensstils, soziale Unterstützung und Stressbewältigungstechniken spielen eine entscheidende Rolle bei der Behandlung und Vorbeugung dieser Störung. Es ist wichtig, sich daran zu erinnern, dass der Weg eines jeden Menschen mit einer rezidivierenden depressiven Störung einzigartig ist. Die Inanspruchnahme professioneller Hilfe, die Aufrechterhaltung einer offenen Kommunikation und die Priorisierung der Selbstfürsorge sind wichtige Schritte zur erfolgreichen Bewältigung dieser Erkrankung.